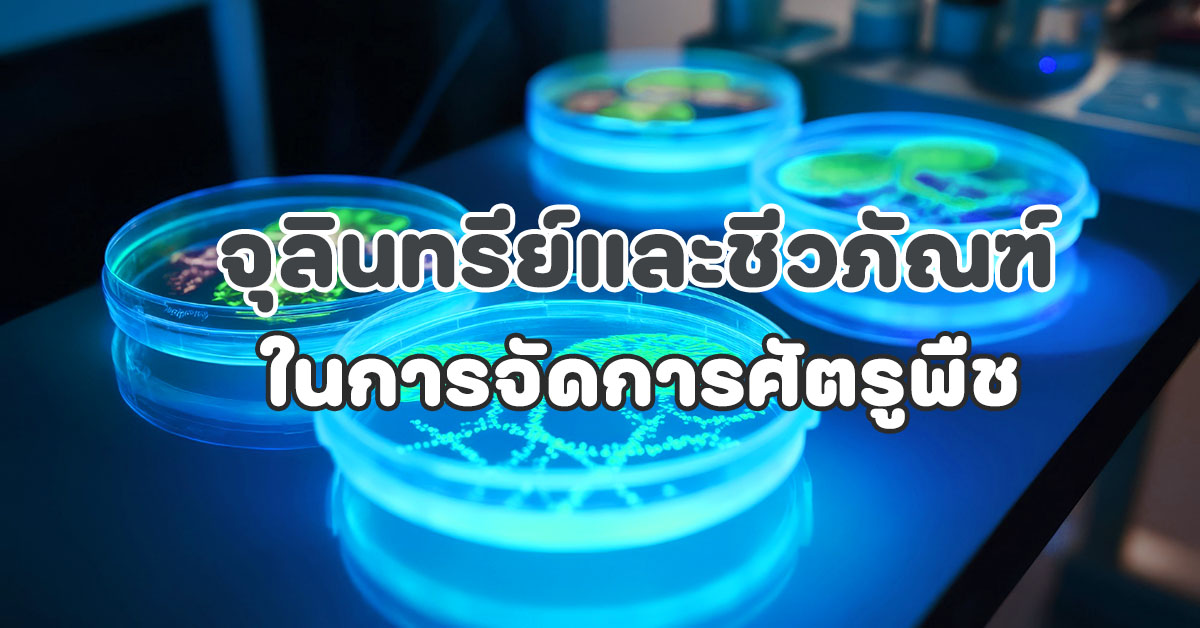

การใช้จุลินทรีย์และชีวภัณฑ์ในการจัดการศัตรูพืช
ช่วยลดการใช้สารเคมีกำจัดศัตรูพืชและส่งเสริมการเกษตรแบบยั่งยืน
การใช้จุลินทรีย์และชีวภัณฑ์ในการจัดการศัตรูพืชเป็นวิธีที่ปลอดภัยและเป็นมิตรต่อสิ่งแวดล้อม ช่วยลดการใช้สารเคมีกำจัดศัตรูพืชและส่งเสริมการเกษตรแบบยั่งยืน จุลินทรีย์และชีวภัณฑ์มีหลายชนิด แต่ละชนิดมีกลไกการทำงานและประสิทธิภาพต่อศัตรูพืชที่แตกต่างกัน ดังนี้:
1. จุลินทรีย์ที่ใช้ในการจัดการศัตรูพืช
จุลินทรีย์ที่นิยมใช้มี 3 กลุ่มหลัก ได้แก่ แบคทีเรีย เชื้อรา และไวรัส
1.1 แบคทีเรีย (Bacteria)
- บาซิลลัส ทูริงจิเอนซิส (Bacillus thuringiensis หรือ Bt): ผลิตสารพิษ Cry proteins ที่ทำลายระบบย่อยอาหารของแมลง สร้างสารพิษที่ทำลายระบบทางเดินอาหารของแมลงศัตรูพืช โดยเฉพาะหนอนผีเสื้อ ตัวอ่อนยุง (Diptera), ด้วงปีกแข็ง (Coleoptera) โดยฉีดพ่นบนใบพืชหรือแหล่งน้ำขัง
- บาซิลลัส ซับทีลิส (Bacillus subtilis): ผลิตสารต้านจุลินทรีย์และกระตุ้นภูมิคุ้มกันพืช ควบคุมโรคพืชที่เกิดจากเชื้อราและแบคทีเรีย โดยการสร้างสารปฏิชีวนะและแข่งขันกับเชื้อโรค การใช้ด้วยการฉีดพ่นหรือคลุกเมล็ดพันธุ์
1.2 เชื้อรา (Fungi)
- บิวเวอเรีย บัสเซียนา (Beauveria bassiana): เจริญเติบโตบนตัวแมลงและผลิตเอนไซม์ทำลายผนังลำตัว เข้าทำลายแมลงศัตรูพืชโดยการแทงทะลุผนังลำตัวและเจริญเติบโตภายในตัวแมลง แมลงศัตรูพืช เช่น เพลี้ย หนอนผีเสื้อ โดยฉีดพ่นบนใบพืชหรือตัวแมลง
- เมททาไรเซียม แอนิโซเพลีย (Metarhizium anisopliae): โจมตีระบบลำตัวของแมลง มีกลไกการทำงานคล้ายกับบิวเวอเรีย บาสเซียน่า แต่มีความจำเพาะต่อแมลงศัตรูพืชบางชนิด แมลงศัตรูพืช เช่น ด้วง ตัวอ่อนแมลงวัน โดยฉีดพ่นหรือผสมกับดิน
- ไตรโคเดอร์มา (Trichoderma spp.): ควบคุมโรคพืชที่เกิดจากเชื้อราในดิน โดยการแข่งขันกับเชื้อโรคและกระตุ้นการเจริญเติบโตของพืช
1.3 ไวรัส (Virus)
- ไวรัส NPV (Nuclear Polyhedrosis Virus): เข้าทำลายแมลงศัตรูพืชโดยการทำให้เกิดโรคในตัวแมลง ทำให้แมลงติดเชื้อและตาย ได้แก่ หนอนผีเสื้อ โดยฉีดพ่นบนใบพืช
2. ชีวภัณฑ์อื่นๆ ที่ใช้ในการจัดการศัตรูพืช
ชีวภัณฑ์อาจรวมถึงสารสกัดจากพืชหรือสารธรรมชาติที่ช่วยควบคุมศัตรูพืช
2.1 สารสกัดจากพืช
- สะเดา (Neem):
- กลไก: มีสารอะซาดิแรคติน (Azadirachtin) ที่รบกวนการเจริญเติบโตของแมลง
- เป้าหมาย: เพลี้ย หนอนผีเสื้อ
- การใช้: ฉีดพ่นบนใบพืช
- ไพรีทรัม (Pyrethrum):
- กลไก: สารสกัดจากดอกไพรีทรัม ทำลายระบบประสาทของแมลง
- เป้าหมาย: แมลงศัตรูพืชทั่วไป
- การใช้: ฉีดพ่นบนใบพืช
# 2.2 สารชีวภาพอื่นๆ
- สปิโนซัด (Spinosad):
- กลไก: สารธรรมชาติจากแบคทีเรีย Saccharopolyspora spinosa ทำลายระบบประสาทของแมลง
- เป้าหมาย: หนอนผีเสื้อ แมลงวันผลไม้
- การใช้: ฉีดพ่นบนใบพืช
3. วิธีการใช้จุลินทรีย์และชีวภัณฑ์
- การฉีดพ่น: ผสมชีวภัณฑ์กับน้ำตามอัตราที่แนะนำและฉีดพ่นบนใบพืชหรือบริเวณที่พบศัตรูพืช
- การคลุกเมล็ดพันธุ์: ใช้จุลินทรีย์คลุกเมล็ดพันธุ์ก่อนปลูกเพื่อป้องกันโรคและแมลง
- การผสมกับดิน: ใช้จุลินทรีย์ผสมกับดินเพื่อควบคุมศัตรูพืชในดิน เช่น ไส้เดือนฝอย
- การวางกับดัก: ใช้กับดักที่มีจุลินทรีย์เพื่อดักจับแมลงศัตรูพืช
4. ข้อดีของการใช้จุลินทรีย์และชีวภัณฑ์
- ปลอดภัยต่อมนุษย์และสิ่งแวดล้อม: ไม่ทิ้งสารพิษตกค้างในดินและน้ำ
- ลดการดื้อยาของแมลง: มีความเฉพาะเจาะจงต่อศัตรูพืช
- ส่งเสริมการเกษตรแบบยั่งยืน: ช่วยรักษาสมดุลของระบบนิเวศ
5. แนวทางการใช้จุลินทรีย์ชีวภัณฑ์อย่างมีประสิทธิภาพ:
- สำรวจและระบุชนิดของศัตรูพืชเป้าหมายให้ถูกต้อง
- เลือกใช้จุลินทรีย์ชีวภัณฑ์ที่มีคุณภาพและได้รับการรับรอง
- ใช้จุลินทรีย์ชีวภัณฑ์ในปริมาณที่เหมาะสมและในช่วงเวลาที่เหมาะสม
- ใช้เทคนิคการพ่นหรือการให้จุลินทรีย์ชีวภัณฑ์ที่เหมาะสมกับชนิดของศัตรูพืชและพืชปลูก
- ติดตามผลการควบคุมศัตรูพืชอย่างสม่ำเสมอและปรับปรุงวิธีการใช้ตามความจำเป็น
การใช้จุลินทรีย์ชีวภัณฑ์เป็นทางเลือกที่ยั่งยืนและเป็นมิตรต่อสิ่งแวดล้อมในการจัดการศัตรูพืช หากเกษตรกรมีความเข้าใจและใช้อย่างถูกต้อง จะสามารถลดการพึ่งพาสารเคมีกำจัดศัตรูพืชและผลิตพืชผลที่มีคุณภาพและปลอดภัยได้
เอกสารประกอบ
การใช้จุลินทรีย์และชีวภัณฑ์ในการจัดการศัตรูพืช กรมส่งเสริมการเกษตร - biological-2563.pdf

PGS นครศรีธรรมราช
เครือข่ายเกษตรอินทรีย์ PGS นครศรีธรรมราช ขับเคลื่อนโดย สมาคมอาหารธรรมชาติยั่งยืน นครศรีธรรมราช
ที่อยู่ : ตำบลควนกลาง อำเภอพิปูน จังหวัดนครศรีธรรมราช
โทร : 0816577283
